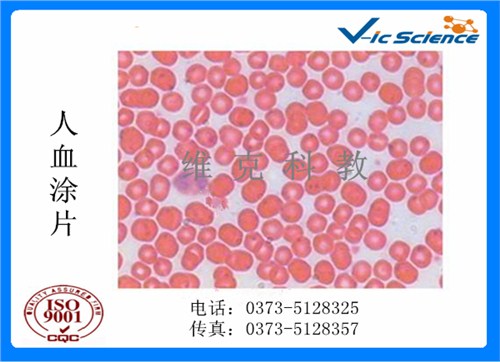

檢測認(rèn)證人脈交流通訊錄
檢測認(rèn)證人脈交流通訊錄
血液檢驗學(xué)切片_品牌_批發(fā)_維克科教供
- 這真不是您需要的產(chǎn)品?
- 品 牌:
- 維克科教
- 主要規(guī)格:
- 25.4*76.2*1.2mm
-
血液檢驗學(xué)切片_品牌_批發(fā)_維克科教供
用于分析和研究血液和造血器官的病理變化,闡述血液系統(tǒng)疾病的發(fā)病機(jī)制,協(xié)助診斷、療效觀察和預(yù)后監(jiān)測的一門學(xué)科。它既屬于血液學(xué)范疇,又屬于檢驗醫(yī)學(xué)的一個分支。實際上,它是以血液學(xué)的理論為基礎(chǔ),以檢驗學(xué)的方法為手段,以臨床血液病為工作對象,創(chuàng)建了一個理論-檢驗-疾病相互結(jié)合、緊密聯(lián)系的新體系,并且在實踐過程中不斷發(fā)展、完善和提高。
產(chǎn)品特點:
我公司的優(yōu)質(zhì)動物切片產(chǎn)品均根據(jù)所要顯示的組織結(jié)構(gòu)選取標(biāo)準(zhǔn)、典型的標(biāo)本材料和正確的取材部位選取材料,取材新鮮、及時無組織自溶、收縮和破裂等現(xiàn)象。切片厚薄均勻,無刀痕、破裂、皺折等現(xiàn)象,粘片平整細(xì)胞組織界限清楚、形態(tài)正常、組織器官著色明顯、清晰、均勻、切片染色對比鮮明。
另外我公司還提供各種切片盒,加工定制各種切片
我公司的優(yōu)質(zhì)動物切片產(chǎn)品均根據(jù)所要顯示的組織結(jié)構(gòu)選取標(biāo)準(zhǔn)、典型的標(biāo)本材料和正確的取材部位選取材料,取材新鮮、及時無組織自溶、收縮和破裂等現(xiàn)象。切片厚薄均勻,無刀痕、破裂、皺折等現(xiàn)象,粘片平整細(xì)胞組織界限清楚、形態(tài)正常、組織器官著色明顯、清晰、均勻、切片染色對比鮮明。
另外我公司還提供各種切片盒,加工定制各種切片,量大從優(yōu)。
血液檢驗學(xué)切片_品牌_批發(fā)_維克科教供
我公司的優(yōu)質(zhì)動物切片產(chǎn)品均根據(jù)所要顯示的組織結(jié)構(gòu)選取標(biāo)準(zhǔn)、典型的標(biāo)本材料和正確的取材部位選取材料,取材新鮮、及時無組織自溶、收縮和破裂等現(xiàn)象。切片厚薄均勻,無刀痕、破裂、皺折等現(xiàn)象,粘片平整細(xì)胞組織界限清楚、形態(tài)正常、組織器官著色明顯、清晰、均勻、切片染色對比鮮明。
新鄉(xiāng)市維克科教儀器有限公司位于河南省新鄉(xiāng)市,公司主要生產(chǎn)和供應(yīng)各類生物顯微玻片、各規(guī)格塑料,木制玻片盒、過濾器、臘葉標(biāo)本、浸制標(biāo)本、模型、顯微鏡、切片機(jī)、電熱套等教學(xué)儀器及耗材。公司產(chǎn)品主要提供給高等院校、科研機(jī)構(gòu),經(jīng)銷商,及個人玩家。產(chǎn)品暢銷全國并常年大量出口到美國、加拿大、智利、俄羅斯、德國、澳大利亞、巴西、馬來西亞、巴基斯坦、迪拜、伊朗、伊拉克、土耳其、日本韓國等全球多個***和地區(qū)。在國內(nèi)外教育行業(yè)中享有較高的知名度和較好的信譽。
“專業(yè)務(wù)實,充滿活力”是本公司銷售團(tuán)隊的一大特色,而“安全快捷”則是本公司物流團(tuán)隊的處事的宗旨
新鄉(xiāng)市維克科教儀器有限公司
吳老師
- 地址:
- 新鄉(xiāng)市金穗大道靖業(yè)公元國際413號
推薦產(chǎn)品
- 生物切片定制價格_套裝優(yōu)惠_出
- 新鄉(xiāng)兒童塑料切片,兒童塑料切
- 河南兒童塑料切片,供應(yīng)商,兒童
- 優(yōu)質(zhì)生物玻片,廠家供應(yīng),生物玻
- 優(yōu)質(zhì)教學(xué)切片標(biāo)本,廠家,公司,
- 深圳教學(xué)標(biāo)本,批發(fā),教學(xué)標(biāo)本生
- 廣州教學(xué)切片_出廠價格_批發(fā)_
- 河北_彩色切片套裝_優(yōu)惠價格_
- 新鄉(xiāng)生物切片定制,生物切片價
- 35片彩色切片套裝尺寸_價格_規(guī)
- 廣州_中學(xué)生物教學(xué)儀器_多少錢
- 中山_教學(xué)用標(biāo)本_定制_哪家好_
- 動植物切片廠家供應(yīng)_批發(fā)_動植
- 正方形蓋玻片規(guī)格_哪家好_定制
- 廣州中藥生藥標(biāo)本_規(guī)格_型號_
亚洲欧美日韩动漫|
一区二区免费在线观看视频|
国产高潮呻吟久久久|
日本道在线观看|
国产精品美女高潮无套|
日韩免费一级片|
亚洲一二三四五六区|
国产精品自拍99|
三上悠亚在线观看视频|
国产在线一级片|
加勒比海盗1在线观看免费国语版|
中文字幕永久在线观看|
免费高清一区二区三区|
神马一区二区三区|
在线免费观看av的网站|
最新中文字幕视频|
69视频免费在线观看|
五月天色婷婷综合|
亚洲精品一区二区三区蜜桃|
天天色综合天天色|
欧美熟妇激情一区二区三区|
午夜久久久久久久久久影院|
久久亚洲精品无码va白人极品|
午夜精品久久久久久久99热黄桃|
北条麻妃在线视频|
亚洲成人网在线播放|
www.久久久久久久|
国产96在线 | 亚洲|
wwwxx日本|
黄色片网站在线播放|
欧美亚洲另类小说|
1024精品视频|
久久久亚洲av波多野结衣|
国产午夜免费福利|
日韩av三级在线|
人妻熟女aⅴ一区二区三区汇编|
一级片免费在线播放|
91精品国产91久久久久麻豆 主演|
人人妻人人玩人人澡人人爽|
1314成人网|
最新av网址在线观看|
日韩高清一二三区|
波多野结衣视频观看|
精品久久久久久久免费人妻|
中文字幕成人动漫|
国产丰满美女做爰|
久久久久久久九九九九|
9色porny|
亚洲精品成人无码熟妇在线|
国产精品系列视频|
亚洲男人天堂av在线|
日韩视频在线免费播放|
人妻av一区二区三区|
久久久久久久久久成人|
91制片厂毛片|
91精品国产吴梦梦|
老牛影视av老牛影视av|
999免费视频|
日本熟伦人妇xxxx|
成熟了的熟妇毛茸茸|
粉嫩精品久久99综合一区|
www.黄色小说.com|
在线能看的av|
在线观看免费不卡av|
欧美日韩一级在线|
xxx在线播放|
秋霞av鲁丝片一区二区|
成人免费视频国产免费|
一二三级黄色片|
亚洲色成人www永久在线观看|
色婷婷av777|
五月婷婷深深爱|
亚洲熟妇av乱码在线观看|
欧美交换国产一区内射|
午夜肉伦伦影院|
天天干天天色天天爽|
成人国产精品久久久网站|
亚欧洲精品视频|
av片免费播放|
成人a v视频|
国产在线一区视频|
中文字幕国产传媒|
青青艹视频在线|
国产激情在线看|
久久精品色妇熟妇丰满人妻|
免费a v网站|
欧美色图校园春色|
www.av网站|
国产精品国产一区二区三区四区
|
日韩在线一级片|
国产成人精品免费看在线播放|
真人bbbbbbbbb毛片|
天天爽夜夜爽夜夜爽|
国产免费视频一区二区三区|
国产日韩久久久|
91精品国产乱码久久久张津瑜|
亚洲天堂网站在线|
亚欧激情乱码久久久久久久久|
日韩中文字幕三区|
9久久9毛片又大又硬又粗|
热久久最新网址|
卡通动漫亚洲综合|
精品在线观看一区|
呻吟揉丰满对白91乃国产区|
中文字幕天天干|
大地资源高清在线视频观看|
国产91丝袜美女在线播放|
国产又粗又长又爽|
国产精品无码一区二区三|
av天堂一区二区|
国产伦精品一区二区三区88av|
婷婷色在线观看|
性xxxx18|
日本不卡视频一区|
朝桐光av一区二区三区|
中文字幕人妻一区二区三区|
一区二区免费在线观看视频|
国产精品边吃奶边做爽|
美女洗澡无遮挡|
91精品久久久久久久久久久久|
中文字幕免费高清|
欧美a在线播放|
视频国产一区二区|
中文字幕在线乱|
国产精品视频网站在线观看|
成人在线国产视频|
免费日韩视频在线观看|
香蕉视频禁止18|
青青草原播放器|
日韩欧美三级在线观看|
无码人妻黑人中文字幕|
97人妻精品一区二区三区视频|
国产精品视频在线观看免费|
成人免费观看在线视频|
扒开伸进免费视频|
亚洲欧美va天堂人熟伦|
91香蕉视频网址|
日韩国产欧美亚洲|
制服丝袜中文字幕第一页|
精品无码m3u8在线观看|
自拍偷拍福利视频|
黄色av免费观看|
中文字幕 亚洲一区|
天天干天天色综合|
99热这里只有精品在线|
免费观看一区二区三区|
国产18无套直看片|
污污污污污污www网站免费|
久久久久久久久久久免费视频|
成人日韩在线视频|
久久精品无码av|
亚洲国产精品成人久久蜜臀|
中文字幕在线播放视频|
农村黄色一级片|
欧美精品成人网|
日韩网红少妇无码视频香港|
国产精品永久久久久久久久久|
日本中文字幕精品|
日本一级片免费|
激情婷婷综合网|
秋霞精品一区二区三区|
欧美 日韩 人妻 高清 中文|
337人体粉嫩噜噜噜|
欧美一级片免费播放|
黄色片免费网址|
国产免费叼嘿网站免费|
欧类av怡春院|
欧美日韩激情四射|
欧美久久久久久久久久久久|
国产伦精品一区二区三区免.费|
中文字幕在线播放一区|
亚洲精品少妇一区二区|
aaaaaaaa毛片|
亚洲AV无码精品国产|
中文字幕av久久爽一区|
久久久久免费精品|
自拍偷拍色综合|
久久久久亚洲AV成人无码国产|
日韩 欧美 自拍|
日韩av影视大全|
www久久久com|
小向美奈子av|
欧美日韩在线观看成人|
精品国产亚洲AV|
日韩一区二区三区四区视频|
黄色影院一级片|
特级西西444www高清大视频|
成人网站免费观看|
激情五月开心婷婷|
亚洲熟妇无码久久精品|
最近中文字幕免费视频|
毛葺葺老太做受视频|
中文字幕一级片|
国产精品情侣呻吟对白视频|
黄色三级视频在线|
亚洲av综合色区无码一二三区
|
国产又粗又猛又爽|
91麻豆精品国产91久久综合|
一级黄色特级片|
免费观看的毛片|
一级性生活视频|
免费无码国产精品|
蜜桃传媒一区二区亚洲|
小明看看成人免费视频|
人妻视频一区二区三区|
国产96在线 | 亚洲|
中文字幕永久在线观看|
2017亚洲天堂|
日韩 国产 在线|
一区二区不卡免费视频|
亚洲怡红院在线|
jjzz黄色片|
欧美精品aaaa|
中文字幕1区2区|
人妻有码中文字幕|
免费av一级片|
成年人在线看片|
色呦呦免费观看|
国产亚洲天堂网|
www.国产黄色|
久久久久久久久久网|
国产精品久久久久久69|
免费观看亚洲视频|
亚洲天堂手机在线|
91xxx视频|
国产精品高潮呻吟AV无码|
影音先锋成人资源网站|
国产口爆吞精一区二区|
给我免费播放片在线观看|
国产欧美日韩成人|
水蜜桃色314在线观看|
精品人妻一区二区三区三区四区|
日韩精品在线观看av|
av av片在线看|
欧美aⅴ在线观看|
五月天激情婷婷|
亚洲综合激情视频|
一本色道久久综合亚洲精品图片|
欧美激情第四页|
国产又粗又长又黄的视频|
无码人妻精品一区二区蜜桃色欲|
国产精品白嫩白嫩大学美女|
一级片免费观看视频|
免费不卡av在线|
中文字幕第10页|
午夜免费一级片|
成人小视频免费看|
在线观看日韩一区二区|
国产精品久久中文字幕|
少妇性l交大片7724com|
久久综合在线观看|
国产又色又爽又高潮免费|
中文有码在线播放|
成熟了的熟妇毛茸茸|
污污污www精品国产网站|
国产第一页在线播放|
天堂а√在线中文在线鲁大师|
一级黄色a毛片|
免费观看成人在线视频|
实拍女处破www免费看|
精品乱码一区内射人妻无码|
两根大肉大捧一进一出好爽视频|
黄色国产在线视频|
日本视频在线观看免费|
国产日本在线播放|
丰满少妇xbxb毛片日本|
天堂中文字幕在线观看|
欧美成人高潮一二区在线看|
欧美日韩人妻精品一区在线|
香蕉影院在线观看|
国产主播在线看|
91激情视频在线观看|
国产视频在线观看视频|
亚洲av无日韩毛片久久|
国产又黄又爽免费视频|
美女又黄又免费的视频|
aaaaaa毛片|
色婷婷综合久久久久中文字幕|
熟女少妇内射日韩亚洲|
依人在线免费视频|
日韩欧美国产成人精品免费|
天堂网在线中文|
久久免费激情视频|
免费日韩视频在线观看|
欧美福利在线视频|
五月婷婷久久久|
中文字幕 人妻熟女|
亚洲欧洲日本精品|
欧美日韩一区二区三区电影|
国产香蕉精品视频|
91午夜交换视频|
国产999免费视频|
久久国产精品视频在线观看|
丁香激情五月少妇|
丰满人妻一区二区三区53视频|
无码人妻精品一区二区50|
欧美成人黄色网址|
国产一区 在线播放|
国产肥白大熟妇bbbb视频|
人妻视频一区二区三区|
无码人妻丰满熟妇区五十路|
成人综合久久网|
男人添女荫道口图片|
小早川怜子一区二区的演员表|
午夜影院福利社|
www.av导航|
成人免费一区二区三区|
国产污片在线观看|
国产精品一区二区小说|
欧美男女爱爱视频|
久久av秘一区二区三区|
精品无人区无码乱码毛片国产|
少妇高潮久久久|
国产又粗又猛又黄又爽|
亚洲精品中文字幕乱码三区91|
一级黄色片国产|
四季av日韩精品一区|
一区二区美女视频|
caoporn国产|
在线看成人av|
麻豆91精品91久久久|
国产精品天天av精麻传媒|
蜜臀av无码一区二区三区|
日韩最新中文字幕|
欧美88888|
www.日本高清视频|
无码一区二区三区在线|
亚洲天堂网一区二区|
国产吃瓜黑料一区二区|
精品人妻一区二区三区免费|
隣の若妻さん波多野结衣|
国产乱淫av片免费|
国产精品久久久久久久久毛片|
欧美日韩综合一区二区三区|
自拍偷拍欧美亚洲|
国产情侣在线视频|
久久国产一级片|
欧美精品久久久久性色|
日韩在线一区视频|
久久黄色片网站|
xxww在线观看|
中文字幕第22页|
毛片毛片毛片毛片毛|
91香蕉视频免费看|
黄色一级免费视频|
精品在线视频免费|
日本少妇性生活|
欧美黑人一区二区|
亚洲自拍一区在线观看|
黄色片视频免费|
亚洲视频在线观看免费视频|
国产精品国产精品国产专区|
国产免费无遮挡|
国产91绿帽单男绿奴|
欧美高清精品一区二区|
国产香蕉精品视频|
日本护士做爰视频|
国产性猛交xx乱|
免费精品在线视频|
99久久99久久精品|
女人天堂av手机在线|
无人在线观看的免费高清视频|
中文字幕成人在线视频|
久草免费新视频|
制服.丝袜.亚洲.中文.综合懂色|
无码人妻精品一区二区三区9厂
|
天堂网av在线播放|
中文字幕人妻熟女在线|
国产精品扒开腿做爽爽|
日韩激情小视频|
全黄性性激高免费视频|
十八禁视频网站在线观看|
91网址在线观看精品|
国产免费av一区|
国产免费一区二区三区最新不卡
|
91ts人妖另类精品系列|
三年中国中文在线观看免费播放|
97免费在线观看视频|
伊人网站在线观看|
色综合久久久久久|
中文字幕人妻一区二区|
国产人妻互换一区二区|
北条麻妃在线一区|
www.99re7.com|
国产一区二区网站|
日本久久久久久久久久|
久久国产高清视频|
看av免费毛片手机播放|
久久久久香蕉视频|
中文字字幕在线中文乱码|
亚洲欧洲国产综合|
长河落日免费高清观看|
岛国大片在线播放|
久久久一区二区三区四区|
中文字幕av网站|
中国极品少妇xxxx|
欧美与动交zoz0z|
亚洲精品在线视频播放|
在线免费a视频|
亚洲天堂美女视频|
 機(jī)構(gòu)登錄
機(jī)構(gòu)登錄
 檢測認(rèn)證人脈交流通訊錄
檢測認(rèn)證人脈交流通訊錄